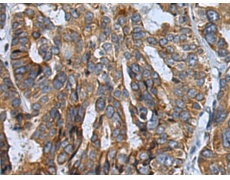
一抗

中文名稱:兔抗CANT1多克隆抗體
別 名: calcium activated nucleotidase 1; DBQD; DBQD1; SCAN1; SHAPY; SCAN-1
相關(guān)類別: 一抗
宿 主: Rabbit
抗 原: CANT1
反應(yīng)種屬: Human, Mouse, Rat
標(biāo) 記 物: Unconjugate
克隆類型: rabbit polyclonal
技術(shù)規(guī)格
|
Background: |
This protein encoded by this gene belongs to the apyrase family. It functions as a calcium-dependent nucleotidase with a preference for UDP. Mutations in this gene are associated with Desbuquois dysplasia with hand anomalies. Alternatively spliced transcript variants have been noted for this gene. |
|
Applications: |
ELISA, WB |
|
Name of antibody: |
CANT1 |
|
Immunogen: |
Fusion protein of human CANT1 |
|
Full name: |
calcium activated nucleotidase 1 |
|
Synonyms: |
DBQD; DBQD1; SCAN1; SHAPY; SCAN-1 |
|
SwissProt: |
Q8WVQ1 |
|
ELISA Recommended dilution: |
5000-10000 |
|
WB Predicted band size: |
45 kDa |
|
WB Positive control: |
Hela and A375 cell lysates |
|
WB Recommended dilution: |
500-2000 |


 購(gòu)物車
購(gòu)物車 幫助
幫助
 021-54845833/15800441009
021-54845833/15800441009